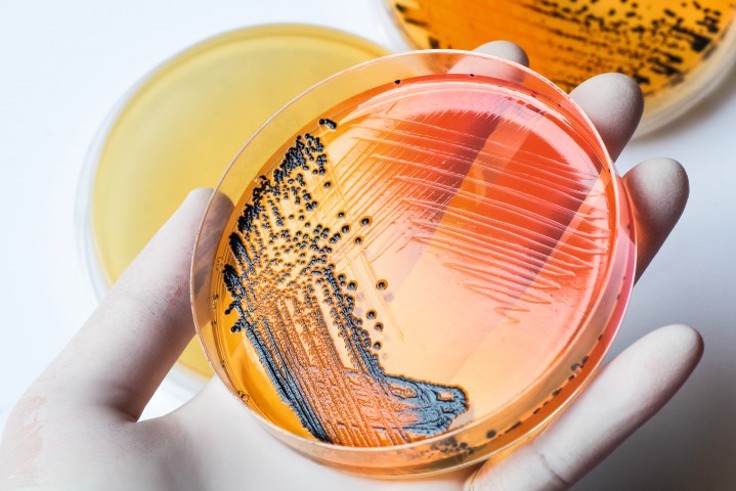

Om salmonella bærerskap-studien (MoMIR)
Artikkel
|Oppdatert
Hvorfor skiller noen ut salmonellabakterier lenge etter at de kjenner seg friske?
Det er lite kjent hvorfor noen personer skiller ut salmonellabakterier fra tarmen over lengre tid enn andre, men nyere studier viser at alder, kosthold eller bruk av medisiner kan ha en betydning. Andre studier antyder at egenskaper hos selve bakterien også kan spille inn, og at det kan være vanskeligere å kvitte seg med noen typer av salmonellabakterier. Sammensetningen av normale tarmbakterier varierer fra person til person og ser også ut til å virke inn på hvor lang tid det går før man kvitter seg med salmonellabakterien.
Formål
Studien har to formål:
1. Kartlegge hvor mange personer som har gjennomgått en salmonellainfeksjon som skiller ut salmonellabakteriene med avføringen sin, selv om de har blitt symptomfrie og føler seg friske.
2. Finne ut hvilke faktorer det er som påvirker at dette (ref. punkt 1) skjer.
Hvem inviteres til å delta?
Alle personer som er bosatt i Norge og som fikk påvist salmonellainfeksjon i tidsperioden 1. januar 2019-31. desember 2019 har blitt invitert til å delta i studien. Både barn og voksne har blitt invitert.
Hva innebærer deltakelse i studien?
Deltakere i studien har blitt bedt om følgende:
- Lese tilsendt informasjonsbrev og signere et samtykkeskjema (for barn over 16 år må begge foresatte samtykke) enten på papir (nederst i informasjonsbrevet) eller elektronisk (uio.no).
- Ta en avføringsprøve cirka fem uker etter den første positive salmonellaprøven ble tatt (dette tar cirka 5 minutter)
- Sende prøven til oss i Folkehelseinstituttet
- Besvare et spørreskjema enten på eller elektronisk (uio.no). Tidsbruk: cirka 15 minutter.
Alle inviterte har fått tilsendt et invitasjonsbrev med et unikt deltakernummer. I brevet bes alle om å enten samtykke til å delta i eller å melde seg ut av studien. Innsending av samtykke har vært mulig enten via en elektronisk link eller et papirskjema som har vært vedlagt invitasjonsbrevet.
Alle som har samtykket til å delta har fått tilsendt et brev med prøvetakingsutstyr og detaljerte instrukser om prøvetaking. Deltakerne har deretter sendt prøven til Folkehelseinstituttet i den vedlagte frankerte konvolutten. Konvolutten, prøverør og spørreskjemaet har kun blitt merket med deltakernummer, sånn at ingen utenfor studien har kunnet vite hvem som har sendt inn prøverør og spørreskjema.
Det har vært mulig å besvare spørreskjemaet enten elektronisk eller på papir. I spørreskjemaet spørres det om alder, kjønn, husstandssammensetning, utdanning, samt opplysninger om salmonellainfeksjonen. Skjemaet inneholder også spørsmål om når sykdommen inntraff og hvor lenge den varte, om andre i husstanden også ble syke, symptomer, eventuell medisinbruk, og sykehusinnleggelse på grunn av salmonellainfeksjonen. Videre stilles det spørsmål om faste medisiner, helsetilstand, reisevirksomhet de siste månedene, kosthold samt kontakt med dyr. Foresatte har kunnet hjelpe til med utfylling og prøvetaking for barn som har deltatt.
Trekning av iPad
Alle deltakerne som har samtykket til å delta i studien, og som har besvart spørreskjemaet og sendte avføringsprøven til Folkehelseinstituttet, har vært med i loddtrekning om en iPad. Vinneren ble kåret i desember 2020 og har blitt kontaktet direkte.
Hvordan analyserer vi innsamlede prøver og svar?
Vi bruker en del av avføringsprøven for å dyrke salmonellabakterier i et laboratorium. Dersom Salmonella vokser frem betyr det at deltakeren fortsatt skiller ut bakteriene. Funnet vil ikke ha konsekvenser for deltakeren men vil gi oss informasjon om hvor mange som har gjennomgått en salmonellainfeksjon som fortsatt skiller ut bakteriene i flere uker etter at de er symptomfrie og føler seg friske.
Hvis Salmonella vokser frem, undersøker vi bakteriens arvestoff for å finne ut om det er noe spesielt med salmonellabakterien som gjør at den blir lengre værende i tarmen enn andre salmonellabakterier. Vi sammenligner også arvestoffet til den nyisolerte bakterien med arvestoffet fra Salmonella-bakterien som vokste frem når deltakeren ble først diagnostisert med Salmonella for å se om det er fortsatt den samme bakterien som er i tarmen.
Resultater
Analyse og sammenstilling av resultatene pågår fremdeles. Prosjektet forventes avsluttet i løpet av første halvår 2022.
Hva får du tilbakemelding om?
Som deltaker vil du ikke få tilbakemelding om dine egne resultater. Grunnen til det er at vi bruker avidentifiserte data i analysene, det vil si opplysninger og resultater uten navn, fødselsnummer eller andre direkte identifiserbare personopplysninger. Dessuten vil enkeltresultatene ikke ha konsekvenser for deltakerne, og for at vi skal kunne besvare studiens problemstilling trenger vi kun de samlede forskningsresultatene.
Når forskningsresultatene er klare, publiseres de i forskningsartikler og på studiens nettside (fhi.no).
Innhenting og lagring av data i særskilte kategorier
I studien har vi innhentet og registrert opplysninger om deltakere ved hjelp av spørreskjema og Norges meldingssystem for smittsomme sykdommer (MSIS). Studien har fått tillatelse fra Skatteetaten til å bruke informasjon i Folkeregisteret for å ta kontakt med aktuelle deltakere.
Leger og laboratoriepersonell er lovpålagt å melde salmonellainfeksjoner til MSIS (Lovdata). Opplysningene i MSIS er taushetsbelagte. Derfor er det MSIS som først har tatt kontakt med aktuelle personer og invitert dem til å delta i studien. Hvis den inviterte har samtykket, har MSIS utlevert registrerte opplysninger om deltakeren til oss, inkludert informasjon om salmonellasykdommen han eller hun har gjennomgått. Opplysningene lagres på en sikker dataserver ved Folkehelseinstituttet. For å samle inn svar og samtykke via elektroniske skjemaer har vi benyttet oss av Universitetet i Oslos «Tjenester for Sensitive data (TSD)». TSD er en forskningsplattform som oppfyller lovens strenge krav til behandling og lagring av sensitive forskningsdata. Elektronisk samtykkeskjema vil kreve innlogging med ID-porten to ganger: først for åpne skjemaet og så for å signere skjemaet elektronisk.
Samtykke- og spørreskjema på papir lagres i låste skap på Folkehelseinstituttet.
Hvem har tilgang til dataene?
Bare noen få medarbeidere i studien har tilgang til de forskjellige dokumentene og databasene og kan koble de sammen. Alle medarbeidere i studien er underlagt taushetsplikt.
Innsamlede data oppbevares i fem år etter studieslutt og anonymiseres eller slettes innen et halvt år etterpå. Gjenværende prøvemateriale destrueres ved studieslutt.
Data som samles inn i studien skal utelukkende benyttes til forskning.
Samtykke til å delta
Det er frivillig å delta i studien. Alle deltakere har måttet signere et samtykkeskjema for å delta. Begge foresatte har måttet samtykke på vegne av barn under 16 år som har deltatt.
Deltakere har når som helst, og uten å oppgi noen grunn, kunnet trekke samtykket tilbake. Dersom man har trukket seg fra prosjektet, har man kunnet kreve å få slettet innsamlede opplysninger om seg selv og sine prøver (med mindre opplysningene allerede er inngått i analyser eller brukt i vitenskapelige publikasjoner).
Kontaktinformasjon
Studien gjennomføres av Folkehelseinstituttet og ledes av seniorforsker Mohammad Umaer Naseer ved avdeling for smitte fra mat, vann og dyr.
Hvis du har spørsmål om studien, kan vi kontaktes på telefon 21 07 70 00.
Tillatelser
Prosjektet er godkjent i Regionale komiteer for medisinsk og helsefaglig forskningsetikk, REK.
Saksnummer i REK er 2018/644; REK sør-øst D.
Finansiering
Prosjektet finansieres av EU og Folkehelseinstituttet, og er en delprosjekt av EU Horizon2020 One Health EJP prosjekt 773830 Monitoring the gut microbiota and immune response to predict, prevent and control zoonoses in humans and livestock in order to minimize the use of antimicrobials (MoMIR-PPC)